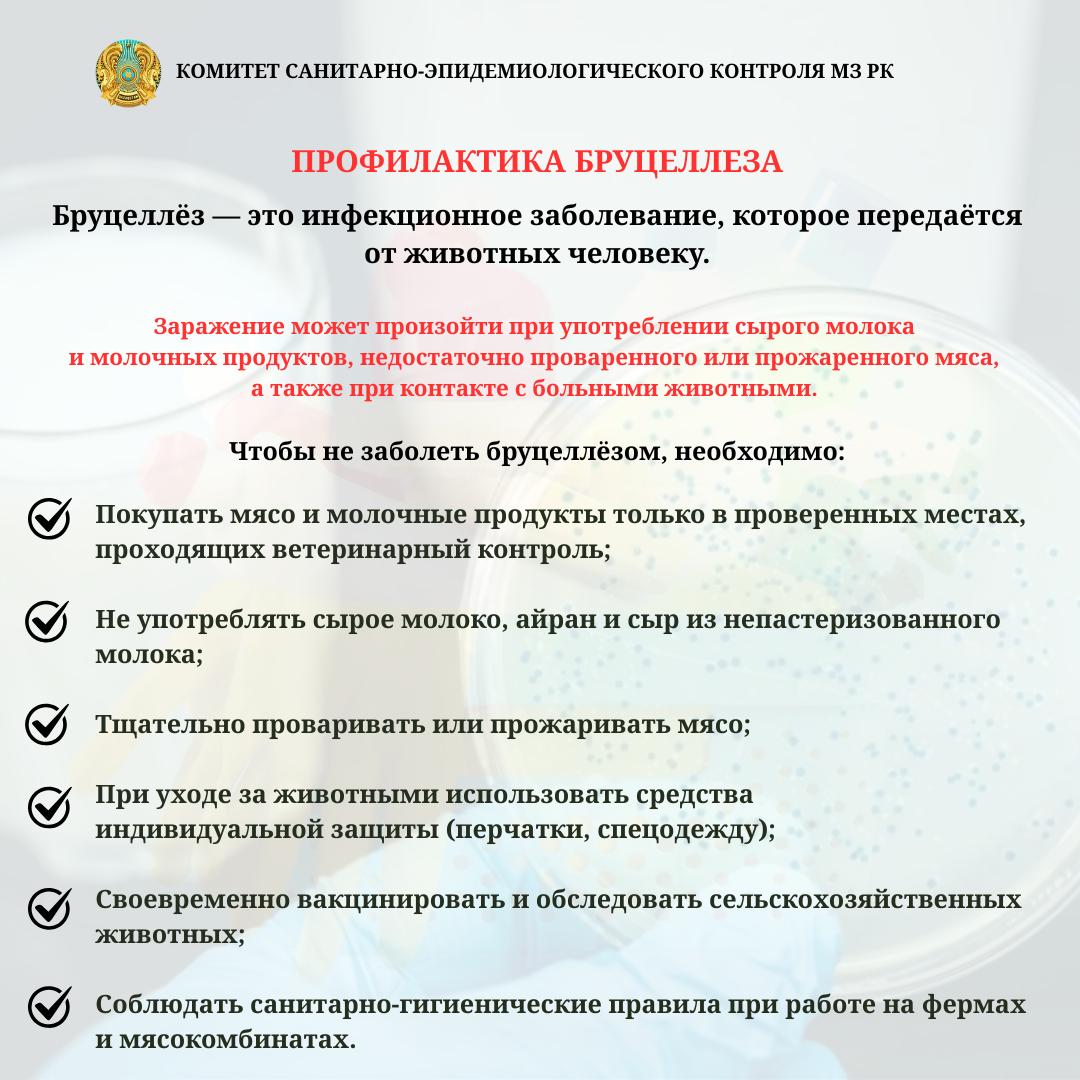
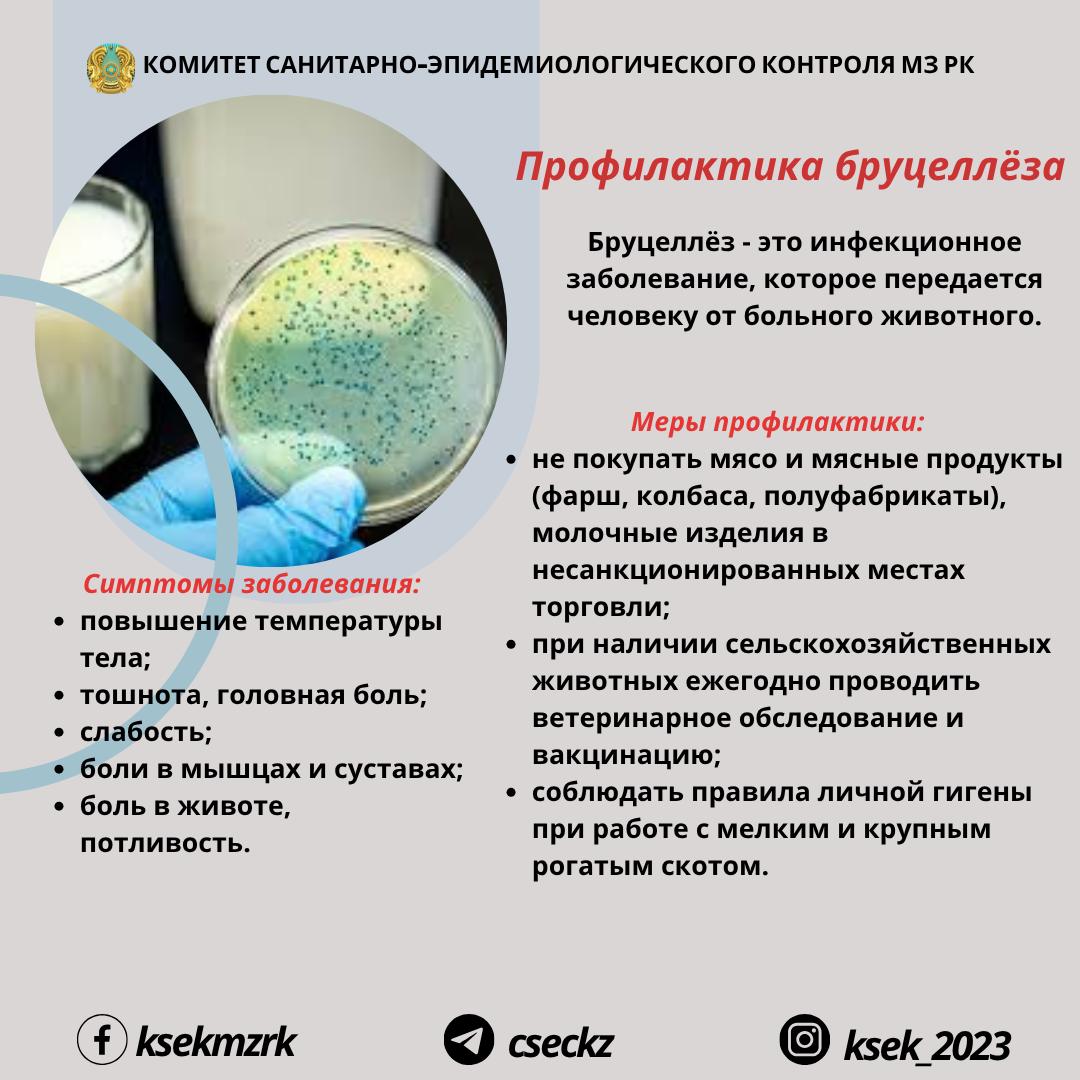
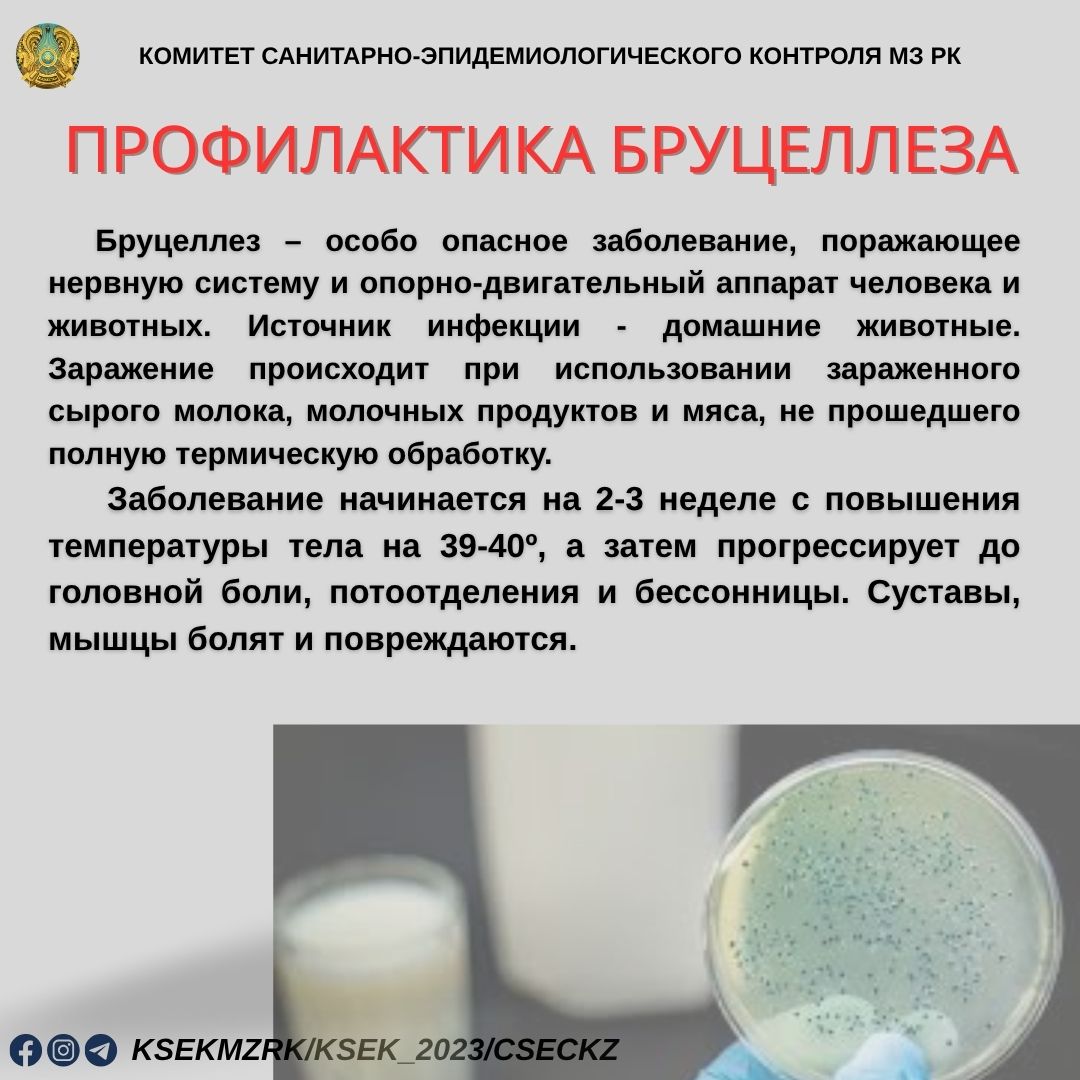

Приказ 533 бруцеллез
Приказ 533 бруцеллез 136 фотографий
Magnimore plus инструкция
Пускатель с катушкой 220 вольт
Заболеть переходный или непереходный
Какая сейчас луна 27 апреля
Поздравить с днем муниципального работника
Прохождения игры вертолеты
Dragon dogma 2 погибель нации
Минпромторг отчетность
Пункт сдэк рыбинск
Старые монеты покажите